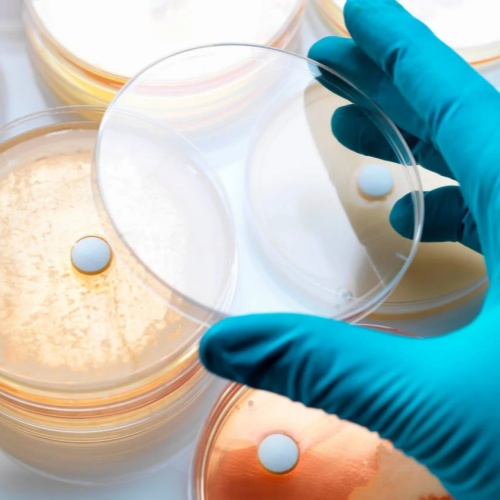

第四代头孢菌素头孢吡肟(Cefepime)迎来了新的固定联合用药伙伴。在成品药Exblifep®中,它与一种新的β-内酰胺酶抑制剂——恩美他唑巴坦(Enmetazobactam)组合使用。该药已获批用于治疗成人复杂性尿路感染和医院获得性肺炎。
一、为什么需要β-内酰胺酶抑制剂
β-内酰胺酶是许多细菌产生的酶,可破坏抗生素中的β-内酰胺环,使青霉素类和头孢菌素类抗生素失效。将β-内酰胺类抗生素与β-内酰胺酶抑制剂固定联合,是延长和恢复抗菌活性的成熟策略。
恩美他唑巴坦正是这样一种新上市的β-内酰胺酶抑制剂。在Exblifep®中,它与第四代头孢菌素头孢吡肟联合使用,由Advanz Pharma公司生产。每瓶用于配制静脉输注溶液的粉针剂含有2 g头孢吡肟和0.5 g恩美他唑巴坦。
二、适应证与给药方式
Exblifep®获批用于以下成人感染:
复杂性尿路感染(cUTI),
医院获得性肺炎(HAP)。
本品仅限静脉输注使用。推荐剂量为头孢吡肟/恩美他唑巴坦 2 g/0.5 g,每8小时一次。
在给药方式上,两种适应证略有不同:
复杂性尿路感染通常在2小时内输注完成;
医院获得性肺炎则建议4小时延长输注,以提高药物在肺组织中的暴露。
上述剂量适用于肾功能正常的患者。如存在肾功能减退,则需根据说明书调整剂量和给药间隔。
三、疗程与特殊人群用药
一般治疗疗程为7至10天,原则上不少于7天,不超过14天。
老年患者原则上不需要单独调整剂量,但由于高龄人群常伴随肾功能下降,用药时应谨慎评估,并在治疗期间监测肾功能。对于同时使用潜在肾毒性药物的患者,同样需要密切随访。
妊娠期仅在获益明显大于潜在风险的情况下,方可考虑使用本品。哺乳期则需在停止哺乳与暂停或避免用药之间做出权衡,同时综合考虑母亲治疗获益和母乳喂养对婴儿的价值。
四、抗菌谱特点:对A类ESBL有效
恩美他唑巴坦主要抑制A类扩展谱β-内酰胺酶(ESBL),但对A类碳青霉烯酶中的**肺炎克雷伯菌碳青霉烯酶(KPC)**抑制作用不可靠。
B、C、D类β-内酰胺酶对恩美他唑巴坦不敏感,因此该组合并非“广谱耐药克星”,其应用仍需基于病原学证据。
在临床研究中,已证实其对以下革兰阴性菌有效:
大肠埃希菌,
肺炎克雷伯菌,
奇异变形杆菌。
体外研究结果提示,对多种肠杆菌科细菌及部分非发酵菌也可能有效,但尚缺乏临床试验证据。肠球菌根据体外数据被认为对该药不敏感。
五、临床研究证据
欧洲药品管理局(EMA)引用的一项研究纳入了1041例复杂性尿路感染成人患者。结果显示,在治疗7至14天后:
头孢吡肟/恩美他唑巴坦组的有效率为79%(345例中273例);
哌拉西林/他唑巴坦组为59%(333例中196例)。
此外,在一项包含19名健康志愿者的研究中证实,该联合制剂能够充分进入肺组织,为其用于肺炎治疗提供了药代动力学依据。
六、初步评价:更多是“类药”而非突破
尽管抗菌药物研发迫切,但从现有证据看,恩美他唑巴坦并未带来明显的机制或抗菌谱突破。其结构与临床应用已久的他唑巴坦高度相似,仅在分子结构上增加了一个甲基。
与哌拉西林/他唑巴坦相比,头孢吡肟/恩美他唑巴坦在研究中显示出一定疗效优势,更可能源于头孢吡肟本身的抗菌活性,而非新型抑制剂的显著贡献。
因此,从当前视角看,该制剂更适合被归类为已有治疗策略的优化组合,而非具有颠覆意义的新型抗生素。